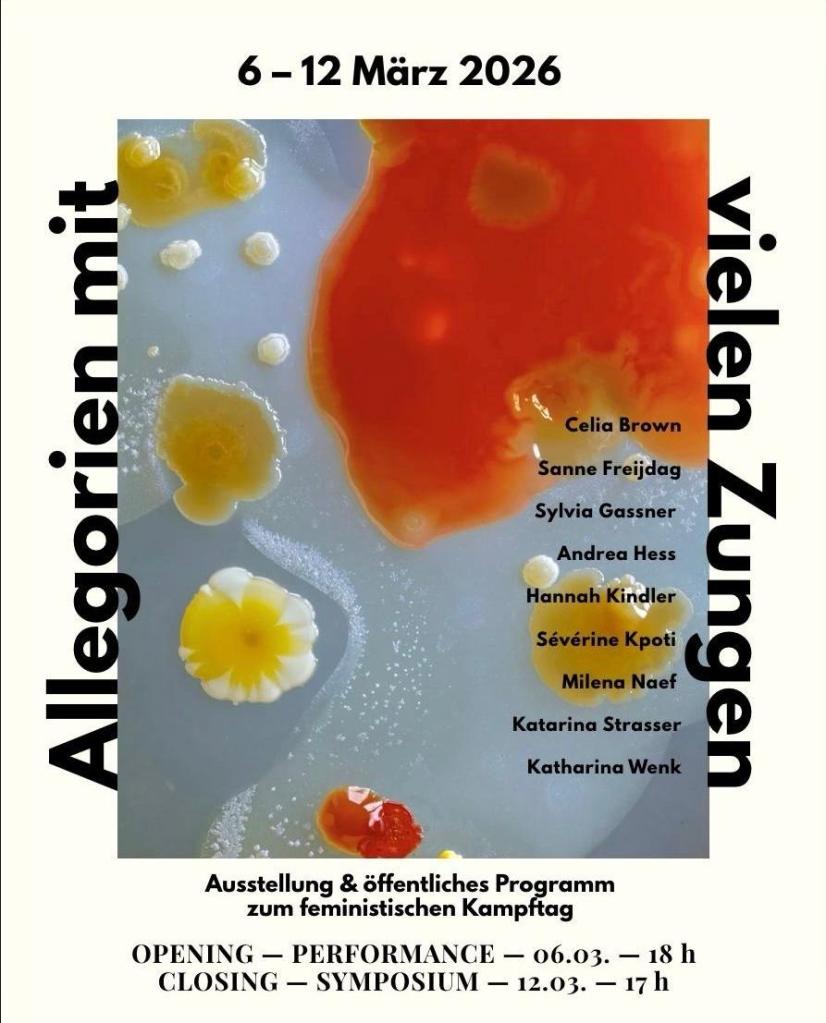

Out Now!
My book is finally out in the world – in print and as a free pdf download (Open Access)! I hope it forms part of a necessary discourse within the art field, on how feminist curating can contribute to the building of a more just and inclusive art sector.
About the book
“Care has become a trend in the art field, but much of the recent curatorial focus seems to be limited to symbolic and representational gestures through exhibitions and public programming. These efforts, however, have led to few (infra)structural changes. The need remains to bring about fair working conditions, gender equity, and support structures for caregivers and care-receivers. In response, Sascia Bailer redefines “curatorial care” as an infrastructural practice grounded in feminist care ethics that provides “care for presence” for diverse practitioners and audiences. Drawing from socially engaged curatorial and artistic practices, the book offers hands-on propositions for constructing caring infrastructures and provides a micro-political roadmap for curating with care.”
For more details and free download of the book click here
Upcoming Events

24.04. – 16.30h
Keynote: “Caring for Infrastructures”
Conference: Caring for Photography, Museum Folkwang

27.04. – 10.15h
Keynote: “Caring Infrastructures”
Annual members conference Mediamus “We Care!”
Aargauer Kunsthaus, CH

08.05. – 12.30 – 13.30h
Online Lunch Talk about the Caring Culture Lab
Event series “Care statt Kitsch”, organized by WAM – Women in Arts and Media & Bühnenmütter* e.V.
Registration via: suedwest@womeninartsandmedia.de
Zoom (Password WAM): https://us06web.zoom.us/j/8735559457?pwd=KzFJRDhhQlQ2MU91TVpkaks0RWQ3Zz09
Past Talks & Workshops
2026
2025
2024
To mark Feminist Day, the artist collective M.A.R.S. – Maternal Artistic Research Studio is presenting the exhibition Allegories with Many Tongues at SCHOPF2 in Freiburg from March 6 to 12, 2026.
Thursday, March 12th, 5–7 p.m. Symposium & Finissage
With contributions from Sascia Bailer, Mari’on Mangelsdorf, Jutta Krauß, and Andrea La Gos, the Töchterkollektiv (Daughters’ Collective), Feministische Geschichtswerkstatt Freiburg (Feminist History Workshop Freiburg), artist talk with Sylvia Gaßner, Milena Naef, Hannah Kindler, Katharina Wenk, Celia Brown, and Andrea Hess; moderated by Johanna Scheibler and Lynn Seifert
Full programme here: https://kreativpioniere-freiburg.de

14.02.2026
WORKSHOP:
Collectively Building Caring Infrastructures
at: Goethe Institute, Johannesburg, South Africa
More here: https://www.instagram.com/p/DT-0MihjHiA/

17.02.2026
Panel: “Parenting, Privilege and the Future of Inclusive Art Economies”
Part of the Motherhood Symposium in the framework of the exhibition Motherhood: Paradox and Duality
at: Iziko South African National Gallery, Cape Town, South Africa
More here: https://www.iziko.org.za/exhibitions/motherhood-paradox-and-duality/
Tuesday, 27.1.26 – 19:30h
feministischer salon basel
“Caring Infrastructures – Fürsorge als gelebte Praxis im Kulturbetrieb”
with Sascia Bailer, Anisha Imhasly, Dominique Grisard (art of intervention)
Morehere
Exhibition: 29.11.25 – 04.01.26
WORKWORKWORK: Dimensions of To Do’s

The Ausstellungsraum Klingental, Basel becomes a multilayered laboratory for the myths and inequalities surrounding work. For what is socially recognised as work is polarising—hereditary wealth, precarious working conditions, unpaid care work, unequal distribution of (free) time and “to-do’s”, as well as neoliberal notions of diligence and laziness intersect the debate. In „WORKWORKWORK: Dimensions of To Do’s,“ the artistic positions critically engage with exhaustion, digitalised work, care work, pregnancy, ecological care, and fair remuneration—and reveal a systemic critique that does not spare the art field.
Curated by Sascia Bailer and Karin Lustenberger
Part of Regionale 26. More here
PUBLIC PROGRAM
29.11., 16:30
Vernissage
with opening speech by the curators and the performances
13.12., 14:00–18:30
SPARK THE FLAME!
participatory outdoor performance format at the fire for adults and children, with artistic interventions
&
“(Un)paid Work in the Arts – Who Bakes the Cake?”
moderated panel
21.12., 16:30
Public guided tour
as part of the Regionale bus tour from Freiburg
More here

Panel on Caring Structures at ICOM Annual Conference, Hamburg
December 3-5, 2025
More here
Curating Differently
October 28th, 2025
Bern, organized by The Art of Intervention
Panel on art, care and motherhood
October 2nd, 2025
Kulturhaus Villa Sträuli, Winterthur
Participation in exhibition programme “SOFT INTENTIONS” with an audio intervention
Saturday, July 19th
Kunsthafen / Kunsthaus Rhenania, Köln
More here
Performative Walking Workshop “Beyond Monocultures” with Field Narratives
Saturday, July 12th, 2025, 10.30-14h,
M.1 Arthur Boskamp-Stiftung, Hohenlockstedt
More here
Litfass live – STIMMEN on air with Dr. Sascia Bailer
Sunday, July 6, 2025, 18.30h
More here
Panel “The Current Situation of Women in the Arts”
Friday, July 4th, 19h
Galerie Pforzheim / Kunstmuseum der Stadt Pforzheim
More here
Parenting in the Arts Symposium
Thursday, July 3, 2025
Performative Lecture & Workshop,
Kunstverein München, Haus der Kunst München
Organized by The Artist and the Others
More here
Talk with Marcia Breuer (Mehr Mütter für die Kunst.)
June 28, 2025, 17h
Modos Dever, Leipzig
Moderation of Arts Network Meeting
June 28, 2025, 17h
Die Leserinnen Podcast: Mütter, Care und Kunstbetrieb – unvereinbar?
Mit Sascia Bailer
Folge zum Muttertag, Mai 2025
Keynote on anti-discrimination practices within music education
April 8, 2025, 19.00h
Basel Academy of Music
Online Lecture on Caring Infrastructures
For Art Working Parents Alliance (UK) around Hettie Judah and Jo Harrison
March 21, 15h (Berlin time), 2025
Video session – please register here: https://www.outsavvy.com/event/26061/sascia-bailer-caring-infrastructures
Exhibition
“Bodies of Ambivalence”
14 February 2025 – 8 March 2025
Gallery 146 Contemporary (Belelallee 146, 22297 Hamburg)

Opening & artist talk:
Friday, 14 February 2025 at 18:00
Conversation “Labour of Love” with Clara Alisch, Marcia Breuer and Franziska Burkhardt, moderated by Sascia Bailer

Book Launch “Caring Infrastructures”
February 15, 2025
15.30 – 18.00h
M.1 Arthur Boskamp-Stiftung, Hohenlockstedt
“Performing Care”
February 17, 2025
M*Halle, Schwerin, organized by Bühnenmütter e.V.
Caring F*utures. Micro Symposium on Art and Care.
March 12, 2025
Kunsthochschule Münster
Moderierte Lesung “Alle_Zeit” mit Teresa Bücker (Dec 4th, 17.30h)
JMU: Alte Universität, Domerschulstraße 16 Würzburg , Raum: HS1
Lecture: Caring Infrastructures: Impulse für einen gerechteren und fürsorglicheren Kreativsektorschaffen (Dec 2nd, 19.30h)
Venue: THWS Standort SHL, Sanderheinrichsleitenweg 20, 97074 Würzburg , Raum: Fotostudio der Fakultät Gestaltung

A Stuttgart-based programme by the collective Mothers*, Warriors, and Poets (Sascia Bailer, Anna Gohmert, Renate Liebel, Marie Lienhard & Didem Yacizi) that highlights the power of the many feminist networks and alliances and advocates for gender justice and the visibility of artists with care responsibilities. With an exhibition, network meetings, panel discussions and a fanzine, we are working towards more equitable infrastructures in the art field – putting care and solidarity at the centre.

| Exhibition “On the Horizon: Care” |
| On the Horizon: Care was a discursive exhibition that gathered works from artists who challenge these biases. These artists, whether working in collective constellations or as individuals, interrogated the present-day inequities, invisibilities, and exhaustion in caregiving, while striving towards a future where care is fully realized. The show was on view until November 23 at GEDOK Galerie Stuttgart. Co-curated with Didem Yazici as part of the collective Mothers*, Warriors, and Poets. |

| First Arts & Care Assemblyat GEDOK Galerie Stuttgart |
| Over the past five years, our community focused on art, care, and motherhood* has continuously grown, advocating for a more equitable art sector. At this first assembly on Nov 16, we brought together Arts + Care initiatives from Germany and Switzerland to learn about ongoing work, consolidate efforts, and to launch new collaborative projects. A key aim of the meeting was to further develop the CARING CULTURE LAB as a competence center for more equity in the arts. Co-organized with Marie Lienhard as part of the collective Mothers*, Warriors, and Poets. |

| Panel “Networks of Care”at Kunstmuseum Stuttgart |
| Despite its progressive self-image, the cultural sector remains deeply unequal in terms of gender: the gender pay gap is 30 % in this field, compared to 18 % nationwide. Parents, especially mothers*, face particular discrimination due to their caregiving responsibilities. On Nov 16th, this panel brought together initiators of care networks and experts to explore how the art sector can become more parent-friendly and equitable. |
Keynote: Yes, we care! Künstlerinnen* zwischen Sorgearbeit und Kunstschaffen (Sept 27)
fair share! Sichtbarkeit für Künstlerinnen e.V.
Hamburger Bahnhof – Nationalgalerie der Gegenwart, Berlin

Lecture & Workshop: Kunst & Care – Gibt es Lücken? (Sept 18)
with Dominique Grisard & Karin Lustenberger
Soirée Visionnare, Visarte Basel and “art+care”

Workshop: Care for Caregivers: Wie künstlerische Arbeit mit Sorgeverantwortung zusammengehen kann (June 24, 11.30am)
HSLU Luzern

Lecture & Q&A: Kitchen Politics: How to Not Exclude Artists and Cultural Workers with Caring Responsibilities (May 27)
re:publica Berlin, “Who Cares?”

Keynote: Curating with Care (May 15)
#StopHatredNow, Urban Apa, Finland
Workshop: Situated & Relational: Curating Across Generations (May 9 – internal)
NIDA Art Colony, Vilnius, Lithuania

Talk & Workshop: Participating as Parents: How Can the Artworld Better Support Caregivers?
(May 3-4)
with Hettie Judah and Mirthe Berentsen
Conference “Tell Them I Said No”
E-Werk Luckenwalde, Germany

Talk & Panel: Curating with Care (April 25-26)
Conference “City of Women,” Ljubljana, Slovenia
The Art of Caring: Aesthetics & Practices
with Yvonne Volkart, Helen V. Pritchard & Mariana Tilly
Fondation Beyeler & Institut Kunst FHNW, Basel

Workshop: Collective Manifesto-Writing for a more caring cultural sector
Netzhdk at Zürcher Hochschule der Künste, Zürich
Register here: https://netzhdk.ch/agenda

Talk: Care for Presence
Kunstuniversität Graz, Austria
Workshop: Care for Caregivers
Staatliche Akademie der Künste, Stuttgart (Klasse Prof. Katrin Ströbel)

Talk: Care, Gender, Curating
Kunsthalle Bielefeld, Germany
Workshop: Creating Caring Culture
Temporary Gallery, Köln & LabK Düsseldorf
*Cancelled due to strike of Deutsche Bahn*
Talk: Care for Presence
Panel with Prof. Nora Sternfeld, Prof. Joachim Bauer, Dr. Sarah Hübscher
Conference “Expressionism Now!”
Museum Ostwall, Dortmund, Germany

2023
Roundtable: Curating Difference – Different Curating?
The Art of Intervention
Kunstmuseum Basel, Switzerland
Talk: Transforming the Arts with Caring Infrastructures
OnCurating, Zurich University of the Arts, Switzerland
Talk: Art, Curating, Care
Alumni Network of Zurich University of the Arts, Switzerland
Moderator of Panel Discussion: On Art and Motherhood
with Ruchika Wason Singh, Renate Liebel and Marcia Breuer (Online)
Künstler*innenhaus Frise, Hamburg, Germany
Workshop: Art, Curating, Care
LabK Düsseldorf, Germany

Talk: Beyond the Symbolic: On Building Caring Infrastructures Within the Arts
Symposium: „Present Tense – Working in Critical Times“ by Kunstbüro BW & OnCurating,
HfG Karlsruhe, Germany

Workshop: Building Caring Infrastructures Within the Arts
TBA21 Cordoba, Spain & OnCurating

Opening Speech: Art with Care
Platform for Performing Arts
Alte Feuerwache, Berlin, Germany
Workshop: Planting: On Symbiotic Neighborhoods
with Field Narratives
Gropius Bau, Berlin
2022

Workshop: Building Caring Infrastructures – Towards Care As Lived Practice Within The Arts
Kunstbüro Baden-Württemberg, Stuttgart, Germany
Panel: Practices to Heal and Learn
With Sascia Bailer, Daniela Brasil, Sabina Enéa Téari, Karim-Yassin Goessinger, moderated by Juliana Rabelo
INSTAR (Instituto Hannah Arendt for Artivism, Cuba)
documenta fifteen, Kassel, Germany
Workshop: Care as Method: Exploring Curatorial Support Structures
CAMP Notes on Education & OnCurating
documenta fifteen, Kassel, Germany

Talk: Who takes care of those who care? Art, curatorship and the crisis of care
(Original Title: “Quien cuida a los que cuidan? Arte, curaduria y la crisis del cuidado”), moderated by Juliana Rabelo. Part of #AKDmicas, INSTAR – Instituto Hannah Arendt for Artivism, Cuba
Talk: Care as Method
Kunstverein Bielefeld, Germany
2021
Talk: How does Art Care (and for Whom)?
Panel with Sara Rivera; Goethe Institut Indonesien
Talk: Concept of Art in Public Space for Saarbrücken
Panel with transparadiso and Enrico Lunghi
Kulturamt der Stadt Saarbrücken, Germany
Talk: Curating with Care
Artsprogram of Zeppelin University, Friedrichshafen, Germany

Talk: Care as Method
Akademie Kunst und Begegnung
HAU Hebbel am Ufer, Kampnagel und tanz nrw, Berlin, Germany
Talk & Panel: Cut the or between Art and Motherhood
with Hannah Cooke, moderated by Anna Akaltin
Vika e.V. Halle, Germany
Panel: Who Cares?
with Prof. Dr. Paula-Irene Villa, Prof. Dr. Dietmar Süß, Jürgen Kerner, Maximilian Dorner, Sascia Bailer, moderated by Shahrzad Eden Osterer
Friedensstadt Augsburg. Live-streamed from the “Textile and Industry Museum Augsburg to the public radio Bayern 2, Germany

Talk: Care as (Performative) Method
Goethe Institut Indonesien
Talk: Curating with Care
Kunstkommission Saarbrücken
Talk with Field Narratives
Symposium on “How can we situate an artistic and curatorial practice locally in a meaningful way?”
Somalgors74, Tschlin, Switzerland
Talk: Care for Caregivers
Burg Giebichenstein Kunsthochschule Halle, Germany
Talk: Care for Caregivers
CAS and MAS in Curating, Zurich University of the Arts, Switzerland
2020
Roundtable: COVID-19: Pandemics, Care and Communities
With Dr. Edna Bonhomme, The Care Collective, moderated by Prof. João Florêncio
University of Exeter, UK
Talk & Workshop: Contradictions of Curating, Capital and Care
OnCurating, Zurich University of the Arts, Switzerland
Moderation: Symposium: Caring Infrastructures
M.1 Arthur Boskamp-Stiftung, Germany
Introduction and Moderation: Symposium: Caring
with Gilly Karjevsky and Rosario Talevi
Haus der Kulturen der Welt and M.1 Arthur Boskamp-Stiftung, Germany
Moderation: Curatorial Talk with Nora Sternfeld
Symposium: Contemporary Art Biennials- Our Hegemonic Machines in States of Emergency, OnCurating, Zurich University of the Arts, Switzerland